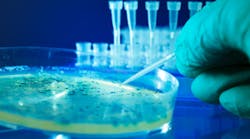
Content Dam Diq Online Articles 2017 02 Bacterial Colonies Dreamstime Thumb Content Dam Diq Online Articles 2017 02 Bacterial Colonies Dreamstime Thumb

Bacterial testing as a risk assessment tool for periodontal disease
Dr. Richard H. Nagelberg explores the protocol of using salivary testing as a risk assessment and prevention strategy to control specific bacteria before clinical evidence of periodontal disease occurs. He emphasizes the real-world benefits that bacterial testing would have on patients.
A few blog posts ago, I proposed an idea of using bacterial testing as a prevention strategy. Patients without periodontal disease would be tested using this protocol, and the bacteria revealed by the test would then be controlled before clinical evidence of periodontal disease occurs. The thought process behind this protocol is identification followed by management of the primary risk factor for periodontal disease development, namely the specific causative bacteria.Lo and behold, a November 2016 study from Odontology tested this theory. (1) The aim of the study was to determine the prevalence of four highly pathogenic periodontal pathogens and the evolution of periodontal disease. The four pathogens examined were specific genotypes of Porphyromonas gingivalis(Pg), Aggregatibacter actinomycetemcomitans(Aa), Treponema denticola(Td), and Tannerella forsythia(Tf). Subgingival plaque samples were taken from 37 patients with chronic periodontitis, 17 with gingivitis, and 60 periodontally healthy individuals. The presence of the four perio pathogens was determined by polymerase chain reaction (PCR). Four years later most of the same individuals were retested.
The authors concluded that specific genotypes of P. gingivalis and T. forsythia increase the risk of an unfavorable evolution of periodontal status. Of course, one study does not prove anything. What it does demonstrate, however, is the viability of an approach such as salivary testing to determine an individual’s risk for developing periodontal disease.
The notched stick tells us nothing about what will be happening in the future. On the other hand, salivary testing may provide some insight into what is coming down the pike for an individual patient. It also provides an opportunity to do something in advance, if necessary, to preserve periodontal and general health. It may be as simple as enhancing the home-care regimen and increasing the frequency of the recare interval. If we are able to head off a chronic, incurable bacterial infection, then we have done something real for our patients.
READ MORE OF DR. NAGELBERG’S BLOGS . . .
Reference
1. Puig-Silla M, Montiel-Company JM, Dasí-Fernández F, Almerich-Silla JM. Prevalence of periodontal pathogens as predictor of the evolution of periodontal status. Odontology. 2016. [Epub ahead of print].
For the most current dental headlines, click here.
About the Author
Richard H. Nagelberg, DDS
Richard H. Nagelberg, DDS, has practiced general dentistry in suburban Philadelphia for more than 30 years. He has served on many advisory boards and as a consultant and key opinion leader for a variety of companies and organizations. Dr. Nagelberg is the Director of Medical Affairs at OraPharma, a division of Bausch Health US, LLC. His practice and other professional activities are centered on the impact dental professionals have beyond the oral cavity. Contact Dr. Nagelberg at [email protected].
Updated May 2022